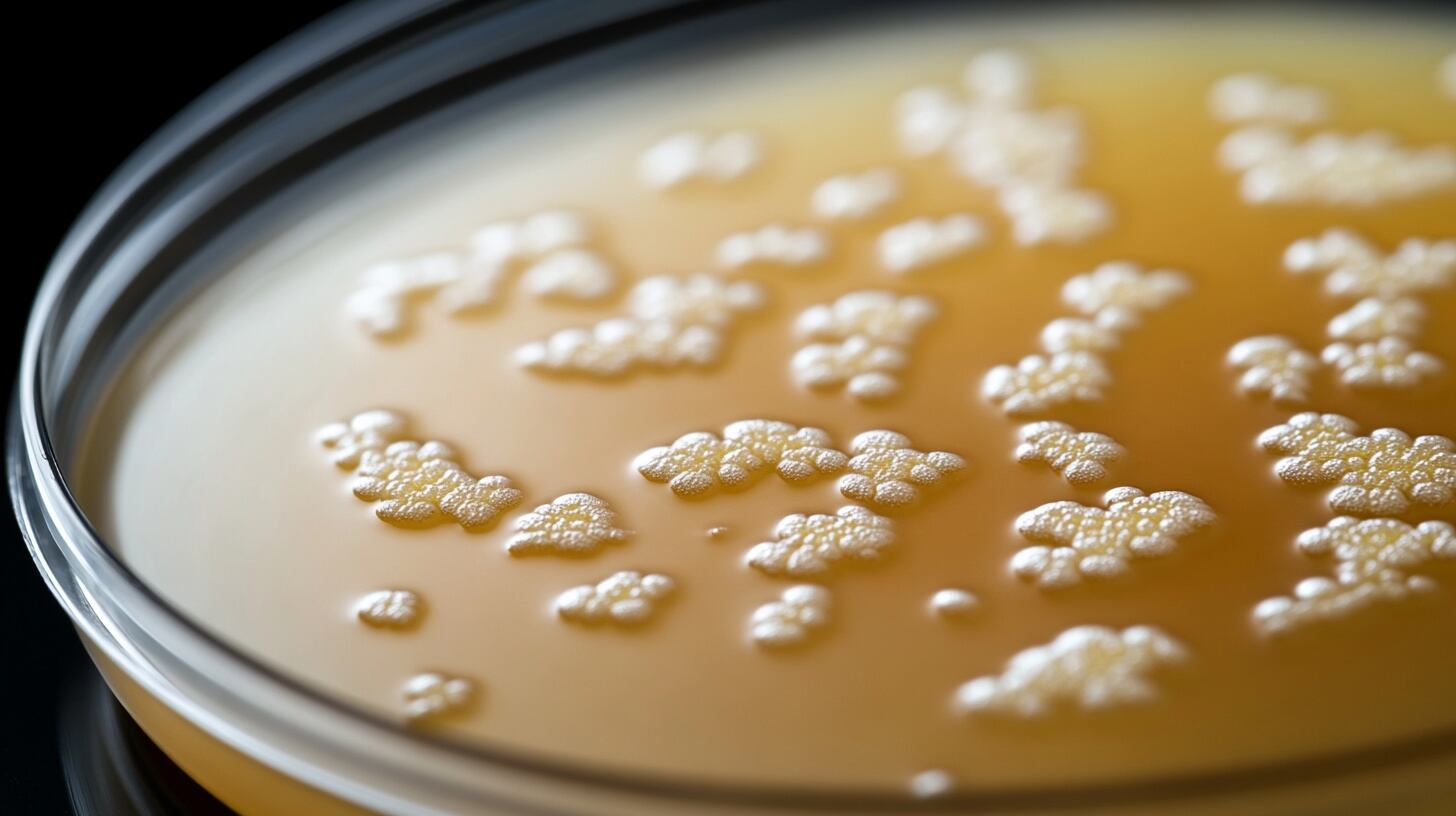
El nuevo compuesto mantuvo su efectividad incluso bajo condiciones que suelen inducir resistencia bacteriana, un avance clave para el tratamiento de infecciones hospitalarias (Imagen Ilustrativa Infobae)

Químicos de la Universidad de Warwick y la Universidad de Monash identificaron un antibiótico con una potencia y eficacia cien veces mayor que otros frente a bacterias resistentes a múltiples fármacos. El hallazgo surge en respuesta a la necesidad de nuevas terapias frente a infecciones hospitalarias graves, que representan se cobran más de un millón de vidas al año.
El antibiótico, denominado pre-metilenomicina C lactona, demostró elevada actividad incluso contra patógenos como Staphylococcus aureus resistente a meticilina (MRSA) y Enterococcus resistente a vancomicina (VRE), bacterias que figuran entre las más peligrosas según organismos internacionales de salud.
La investigación fue desarrollada por el equipo de la Alianza Monash-Warwick Contra las Amenazas de Superbacterias Emergentes. Según el Journal of the American Chemical Society, la Organización Mundial de la Salud y otros organismos advirtieron que la resistencia a los antimicrobianos sigue creciendo mientras escasean los nuevos antibióticos en desarrollo, en parte por el elevado coste y la baja rentabilidad para la industria farmacéutica.

El estudio pone de relieve una estrategia novedosa: explorar los intermediarios químicos presentes en la biosíntesis de compuestos naturales, un área poco explotada en comparación con la búsqueda tradicional de antibióticos en nuevas fuentes biológicas.
De acuerdo con el profesor Greg Challis, codirector del estudio y miembro del Departamento de Química de la Universidad de Warwick, el nuevo compuesto se hallaba como intermediario natural durante la producción de metilenomicina A, un antibiótico descubierto hace cincuenta años.
Gracias a la eliminación de determinados genes que intervienen en la ruta biosintética, los científicos lograron aislar dos intermediarios antes desconocidos, entre ellos la pre-metilenomicina C lactona. Ambos demostraron tener mayor poder antibacteriano que la metilenomicina A tradicional.

En las pruebas de laboratorio, la pre-metilenomicina C lactona superó a la metilenomicina A en eficacia por un margen de cien veces, en particular frente a bacterias de tipo Gram positivo. El compuesto resultó especialmente potente contra Staphylococcus aureus y Enterococcus faecium, responsables de infecciones difíciles de tratar en hospitales.
La doctora Lona Alkhalaf, codirectora del equipo, subrayó que el hallazgo resultó inesperado, ya que Streptomyces coelicolor, la bacteria productora, es bien conocida por la comunidad científica y se estudia desde la década de 1950. Los investigadores concluyeron que el propio microorganismo pudo haber evolucionado para fabricar variantes menos activas a lo largo del tiempo, lo que sugiere la existencia de mecanismos biológicos complejos detrás del cambio de compuestos.
Uno de los puntos destacados del estudio consiste en la resistencia bacteriana. El equipo sometió Enterococcus a condiciones comunes que suelen inducir resistencia a antibióticos convencionales, como la vancomicina, sin observar que el nuevo compuesto perdiera efectividad. La OMS reconoce a las bacterias resistentes a la vancomicina como prioridad máxima para el desarrollo de nuevos tratamientos, debido al riesgo que implican en servicios de salud y cuidados intensivos.

La investigación ofrece, además, un procedimiento sintético viable para producir el compuesto a escala. Según el profesor David Lupton, de la Universidad de Monash, la síntesis controlada permitirá crear variantes y estudiar en detalle la relación entre estructura y actividad. Esta capacidad abre la puerta a modificaciones orientadas a optimizar la eficacia y seguridad del antibiótico antes de ensayarlo en modelos más avanzados.
El siguiente paso para la pre-metilenomicina C lactona será la validación en estudios preclínicos, donde se evaluará su comportamiento en organismos completos y su seguridad para uso en seres humanos. De acuerdo con los autores, la estructura sencilla del compuesto y su método de producción eficiente constituyen ventajas comparativas para la investigación y la eventual fabricación industrial del medicamento.
La aparición de antibióticos totalmente nuevos se considera fundamental en el contexto de la crisis mundial por la resistencia a antimicrobianos. A nivel global, infecciones por bacterias multirresistentes causan un alto número de muertes cada año y significan un reto creciente para los sistemas de salud.
La posibilidad de descubrir fármacos potentes en rutas hasta ahora desestimadas, como los intermediarios biosintéticos, sugiere un cambio de paradigma en la búsqueda de antibióticos. De acuerdo con los científicos citados por Science Daily, la investigación demuestra el valor de revisar compuestos previamente considerados menos relevantes y de reforzar la colaboración internacional en la lucha contra las superbacterias.
Así, la pre-metilenomicina C lactona emerge como un candidato prometedor por su acción potente, su aparente capacidad de evitar la resistencia bacteriana y la viabilidad de su síntesis a gran escala.
Si los ensayos futuros confirman estas ventajas, el compuesto podría contribuir de manera decisiva al tratamiento de infecciones graves y frenar la amenaza global que plantean las bacterias resistentes a múltiples fármacos.